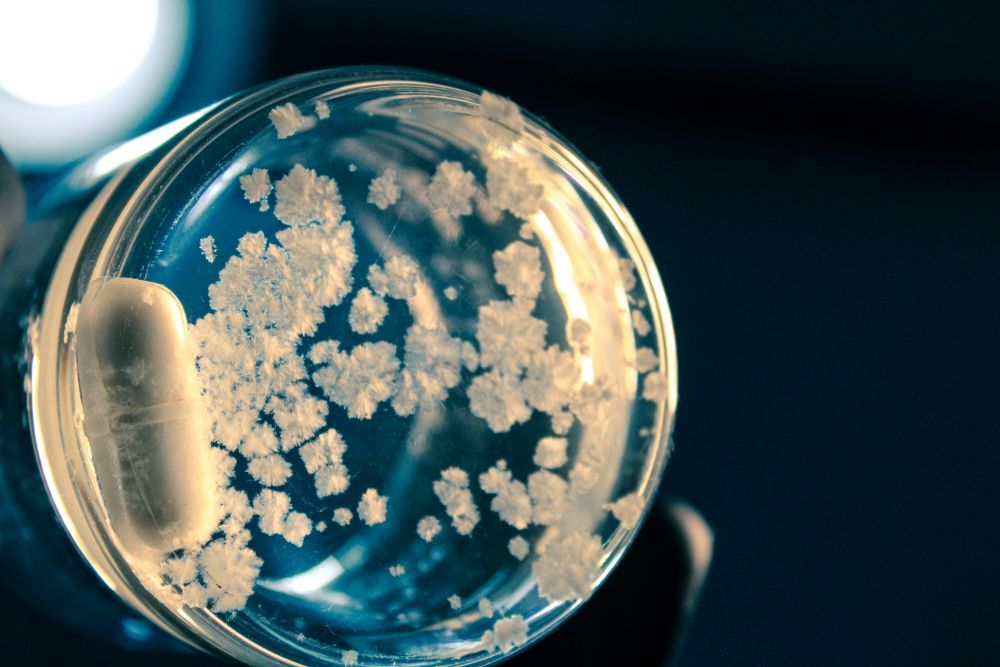

Breath analysis may allow faster detection and monitoring of infections.
A new type of breath test may soon help doctors find bacterial infections much faster than current methods. Researchers are studying a simple approach that looks for signs of bacteria in a person’s breath instead of relying only on blood tests or imaging scans. Early results suggest the test could give answers within minutes, which may help doctors start treatment sooner and reduce the misuse of antibiotics.
Bacterial infections remain a major health problem across the world. Many illnesses, including pneumonia and infections in the blood, muscles, or bones, can become dangerous if not treated quickly. One of the biggest challenges in medicine is figuring out whether symptoms are caused by bacteria, viruses, or other conditions. Doctors often must wait hours or even days for lab results before confirming a diagnosis. During that waiting period, patients may receive antibiotics just in case, even when they might not be needed. This practice contributes to antibiotic resistance, a growing concern in modern healthcare.
The new testing method builds on an older medical idea already used for stomach infections caused by a bacterium known as Helicobacter pylori. In that test, a patient drinks a special liquid containing a harmless substance that bacteria break down. If the bacteria are present, the body releases a traceable gas that appears in the breath and can be measured. Scientists wondered whether a similar method could work for many kinds of bacterial infections throughout the body.
To explore this idea, researchers developed special compounds made from sugars and sugar alcohols marked with a form of carbon called carbon-13. Bacteria process these compounds as part of their normal activity, while human cells mostly ignore them. When bacteria break down the tagged compounds, they release carbon-13 carbon dioxide. This gas travels through the bloodstream to the lungs and leaves the body when the subject breathes out.
The research team tested the method in laboratory animals with several types of infections, including pneumonia and infections affecting bones, muscles, and the bloodstream. After the tagged compounds were given through an injection, scientists measured the animals’ breath using a device that detects the labeled gas. In infected animals, higher levels of carbon-13 appeared quickly, often within about ten minutes. Healthy animals showed little or no sign of the labeled gas, suggesting the test was able to tell the difference between infected and non-infected subjects.
The study also showed another possible benefit. In animals treated with antibiotics for an E. coli infection, the amount of labeled gas in the breath dropped as bacterial levels decreased. This finding suggests the test might help doctors track whether treatment is working, instead of waiting for symptoms alone to improve. A fast way to monitor progress could allow medical teams to adjust medications sooner if needed.
Current tools for diagnosing infections each have drawbacks. Blood cultures can take days to grow bacteria. Imaging scans may show inflammation but cannot always identify the cause. Molecular tests can be accurate but may require specialized equipment and high costs. A breath test, by comparison, could be portable, simple to perform, and less invasive for patients. Because breath samples are easy to collect, the method might also work well in emergency rooms or urgent care clinics where time matters most.
Researchers note that the compounds used in testing are already considered safe, which raises the possibility of future human studies. More work is still needed before the method becomes part of everyday medical care. Scientists must confirm that the test works reliably in people and across many types of infections. They also need to refine the process so results remain accurate in real clinical settings.
Even so, the early findings point toward a different way of diagnosing illness. Instead of waiting for bacteria to grow in a lab dish, doctors may one day detect infection by analyzing what patients breathe out. Faster answers could help reduce unnecessary antibiotic use, support better treatment decisions, and improve care for patients facing serious infections. The research team has filed a patent related to the technology, showing confidence that breath-based testing may play a larger role in future medicine.
Sources:
New breath test could quickly diagnose bacterial infections
Detecting Bacteria in Their Mammalian Hosts Using Metabolism-Targeted [13C]CO2 Breath Testing


Join the conversation!